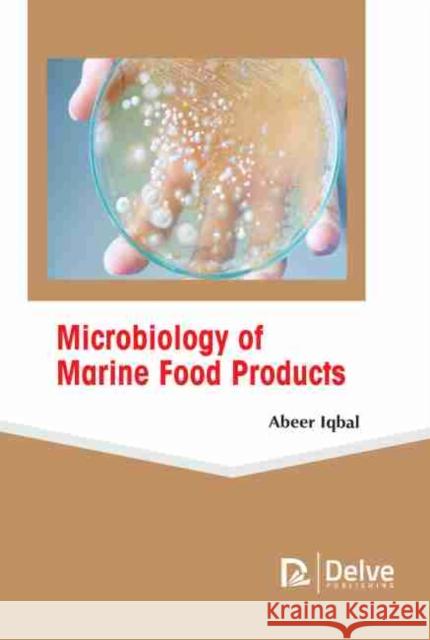
Microbiology of Marine Food Products  9781774077245 Arcler Education Inc

» książki » Cooking - General
 |
The Future of Food Tourism: Foodies, Experiences, Exclusivity, Visions and Political Capital
ISBN: 9781845415389 / Angielski / Twarda / 304 str. Termin realizacji zamówienia: ok. 5-8 dni roboczych. This book presents a systematic and pattern-based explanation of food tourism, focusing on how and why change could occur and what the implications could be. In the future will food tourism involve food grown in the laboratory or a more authentic experience associated with place and history? The book's approach to the future has focused on explanation; the contributors look for the causes, trends and theoretical concepts that explain change, thus attempting to justify and explore the future. Scenarios are used to explore alternative futures and the book examines the implications for the... This book presents a systematic and pattern-based explanation of food tourism, focusing on how and why change could occur and what the implications... |
cena:
641,56 |
 |
Gourmet and Health-Promoting Specialty Oils
ISBN: 9781893997974 / Angielski / Twarda / 596 str. Termin realizacji zamówienia: ok. 5-8 dni roboczych. The third volume in the AOCS PRESS MONOGRAPH SERIES ON OILSEEDS is a unique blend of information focusing on edible oils. These oils contain either unique flavor components that have lead to their being considered "gourmet oils," or contain unique health-promoting chemical components. Each chapter covers processing, edible and non-edible applications, lipids, health benefits, and more related to each type of oil.
The third volume in the AOCS PRESS MONOGRAPH SERIES ON OILSEEDS is a unique blend of information focusing on edible oils. These oils contain either un...
|
cena:
643,87 |
 |
Fruit Processing
ISBN: 9781461358756 / Angielski / Miękka / 248 str. Termin realizacji zamówienia: ok. 5-8 dni roboczych. Fruit and fruit products, in all their many varieties and variations, are major world commodities and part of the economic life blood of many countries, particularly in the developing world. The perception of the healthy nature of fruit is a major reason for its increased consumption in the developed world, and many consumers today find a wider selection of fruit varieties, available at all times of the year, than ever before. This volume, however, is not so much concerned with fresh fruit as those principal areas of processing to which it may be subjected. Fruit processing arose as a means...
Fruit and fruit products, in all their many varieties and variations, are major world commodities and part of the economic life blood of many countrie...
|
cena:
645,58 |
 |
Wine Analysis and Production
ISBN: 9781475769807 / Angielski / Miękka / 621 str. Termin realizacji zamówienia: ok. 5-8 dni roboczych. Winemaking as a form of food preseIVation is as old as civilization. Wine has been an integral component of people's daily diet since its discovery and has also played an important role in the development of society, reli- gion, and culture. We are currently drinking the best wines ever produced. We are able to do this because of our increased understanding of grape growing, biochemistry and microbiology of fermentation, our use of ad- vanced technology in production, and our ability to measure the various major and minor components that comprise this fascinating beverage. Historically,...
Winemaking as a form of food preseIVation is as old as civilization. Wine has been an integral component of people's daily diet since its discovery an...
|
cena:
645,58 |
 |
Table Olives: Production and Processing
ISBN: 9781489946850 / Angielski / Miękka / 495 str. Termin realizacji zamówienia: ok. 5-8 dni roboczych. |
cena:
645,58 |
 |
Soy and Soy-Based Foods in Health and Nutrition
ISBN: 9781774077221 / Angielski / Twarda Termin realizacji zamówienia: ok. 5-8 dni roboczych. |
cena:
648,74 |
 |
Personalized Food: From Home Cooking to the Food Industry
ISBN: 9781774076347 / Angielski / Twarda Termin realizacji zamówienia: ok. 5-8 dni roboczych. |
cena:
648,74 |
|
Microbiology of Marine Food Products
ISBN: 9781774077245 / Angielski / Twarda Termin realizacji zamówienia: ok. 5-8 dni roboczych. |
cena:
648,74 |
 |
Food Contamination and Safety
ISBN: 9781774077238 / Angielski / Twarda Termin realizacji zamówienia: ok. 5-8 dni roboczych. |
cena:
648,74 |
 |
Developments in Food Engineering
ISBN: 9781774072165 / Angielski / Twarda Termin realizacji zamówienia: ok. 5-8 dni roboczych. |
cena:
648,74 |
 |
Aging and Diet
ISBN: 9781774076279 / Angielski / Twarda Termin realizacji zamówienia: ok. 5-8 dni roboczych. |
cena:
648,74 |
 |
Food Additive Toxicology
ISBN: 9781774071670 / Angielski / Twarda / 238 str. Termin realizacji zamówienia: ok. 5-8 dni roboczych. |
cena:
648,74 |
 |
Modern Initiatives for Sustainable Food Production
ISBN: 9781774690222 / Angielski / Twarda / 260 str. Termin realizacji zamówienia: ok. 5-8 dni roboczych. |
cena:
648,74 |
 |
Analytical Techniques for Food Biopreservation
ISBN: 9781774690239 / Angielski / Twarda / 254 str. Termin realizacji zamówienia: ok. 5-8 dni roboczych. |
cena:
648,74 |
 |
Food Flavors: Generation, Analysis and Process Influence
ISBN: 9781774690321 / Angielski / Twarda / 252 str. Termin realizacji zamówienia: ok. 5-8 dni roboczych. |
cena:
648,74 |
 |
Physical Properties of Foods
ISBN: 9781774690543 / Angielski / Twarda / 228 str. Termin realizacji zamówienia: ok. 5-8 dni roboczych. |
cena:
648,74 |
 |
Advanced Fermentation and Cell Technology
ISBN: 9781774691007 / Angielski / Twarda / 274 str. Termin realizacji zamówienia: ok. 5-8 dni roboczych. |
cena:
648,74 |
 |
The Halal Food Handbook
ISBN: 9781774691168 / Angielski / Twarda / 325 str. Termin realizacji zamówienia: ok. 5-8 dni roboczych. |
cena:
648,74 |
 |
Handbook of Vegan Studies
ISBN: 9781774691687 / Angielski / Twarda / 265 str. Termin realizacji zamówienia: ok. 5-8 dni roboczych. |
cena:
648,74 |
 |
Carp: Habitat, Management & Diseases
ISBN: 9781613245255 / Angielski / Twarda / 190 str. Termin realizacji zamówienia: ok. 5-8 dni roboczych. Common carp are hugely popular in aquaculture, course angling, commercial fisheries and as an ornamental fish. While their native range extends from the lakes and rivers of Japan to the Danube Basin in Eastern Europe, their usefulness has led to them being introduced to many waterways outside their native range. In this book, the authors present topical research in the study of the habitat, management and diseases of carp. Included in this compilation are the strategic management of the photoperiodic schedule and melatonin profile in the regulation of carp reproduction; invasive parasites of...
Common carp are hugely popular in aquaculture, course angling, commercial fisheries and as an ornamental fish. While their native range extends from t...
|
cena:
658,46 |













